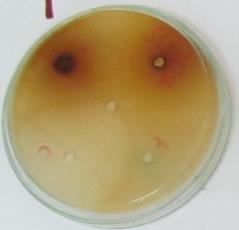
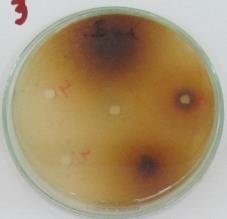
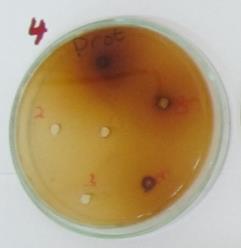
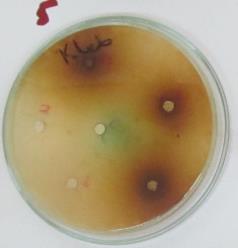
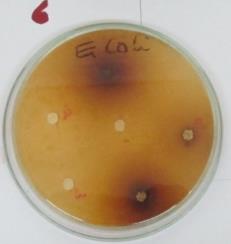
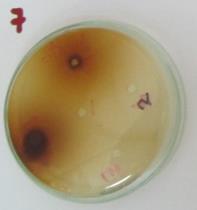
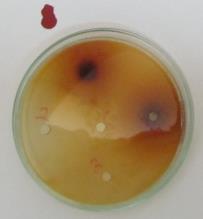
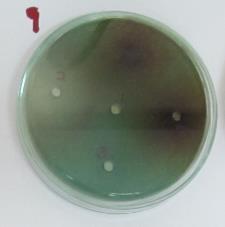

Int J Pharm Pharm Sci, Vol 6, Issue 7, 272-277Original Article
SOLVENT EXTRACTS OF DIFFERENT PARTS OF GHANAIAN PHYLLANTHUS NIRURI SHOW POTENT GROWTH INHIBITION AGAINST SIX HUMAN PATHOGENIC BACTERIA IN VITRO
OSENI LATEEF ADEBAYO*, BANINIAGBEFIA EDWIN
Department of Applied Chemistry & Biochemistry, University For Development Studies, P.O. Box 24, Navrongo campus, Ghana.
Email: lateefoseni@yahoo.com
Received: 04 Apr 2014 Revised and Accepted: 07 May 2014
ABSTRACT
Methods: Whole plant, leaf, stem and root of Phyllanthus niruriwere separately extracted with 70 % ethanol and 70 % methanol and the crude extracts screened for phytochemicals.Six pathogenic microorganisms viz. Klebsiella pneumoniae, Escherichia coli, Pseudomonas aeruginosa, Staphylococcus aureus, Salmonella typhi and Proteus mirabilis were assayed for susceptibility to the various extracts of P. niruri in vitro.
Results: Phytochemical screening of the extracts revealedthe presence of alkaloids, flavonoids, tannins, saponins, steroids, triterpenoids, terpenoids and phenols. Both ethanolic and methanolic extracts showed comparable antimicrobial effects against the selected pathogenic organisms. All the extracts of the plant showed significant (p<0.05) inhibition against all the tested pathogenic microbes at 100 mg mL-1 and 200 mg mL-1. The zones of inhibition of both the plant extracts ranged between 7.5-30.0 mm against the test organisms.Generally, the whole plant extract was the most active against the growth of the bacteria. S. aureuswas the most susceptible organism to the ethanolic extracts (whole plant, leaf, stem and root ethanolic extracts showed respective MIC values of 1.56, 3.125, 6.25 and 6.25 mg mL-1against S. aureus). However, the most resistant bacterium against the ethanolic extracts was P. aeruginosa.
Conclusion: Results from present study reveal that P. niruri contains bioactive compounds with significant antibacterial properties and therefore represents a potential source for the discovery of novel antibacterial agents.
Keywords: Crude extracts, Phyllanthus niruri, Antimicrobial, MIC, Phytochemicals, Pathogenic bacteria, Ghana.
INTRODUCTION
Medicinal plants are part and parcel of humans since the dawn of civilization. Pharmacological studies have acknowledged the value of medicinal plants as potential source of bioactive compounds [1]. Many lead compounds in drug discovery and design are phytochemicals or their modified derivatives [2].
In several countries across the African continent, it is estimated that more than 80% of the population rely on plant-based products to meet their primary health care needs. In recent years, multiple drug resistant human pathogens have increased due to indiscriminate use of synthetic drugs. Bacteria such as Salmonella typhi, Klebsiella pneumoniae, Escherichia coli, Pseudomonas aeruginosa, Proteus mirabilis and Staphylococcus aureus have developed resistance against tothe current best-in-class therapeutic agents. This has resulted in increase in bacteria infections in recent times leading to high mortality rates.
The use of medicinal plants as alternative to common antibiotics has gained prominence among both rural and urban dwellers. In addition, ethno-botanical records suggest that plants are the sleeping giants of the pharmaceutical industry [3]and thus provide a natural source for the discovery of new drugs. This drives the need to screen medicinal plants for novel bioactive compounds as plant based drugs are biodegradable, safe and have fewer side effects [1].
Phyllanthus niruriL, has a long history in herbal medicine throughout the tropics. The natural remedy is usually just a standard infusion or weak decoction of the whole plant or its aerial parts [4]. The plant is mainly used for the treatment of many types of biliary and urinary conditions including kidney and gallbladder stones; for hepatitis, cold, flu, tuberculosis, and other viral infections; liver diseases and disorders including aneamia, jaundice and liver cancer; and for bacterial infections such as cystitis, prostatitis, venereal diseases and urinary tract infections [4]. An aqueous infusion of the whole plant is employed to remedy gonorrhea, syphilis, tuberculosis, cough, diarrhea and vaginitis [5,6]. Most indigenous people particularly in the Ewe, Ga and the Akan communities of Ghana use a decoction of various parts of P. niruri for treatingseveral bacteria infections. The current studycompares bacteria growth inhibition activity of solvent extracts ofvarious parts of Ghanaian P. niruri. Minimum Inhibitory Concentration (MIC) of the most active extract was determined using six human pathogenic bacteria in vitro.In addition, the extracts were also screened for possible bioactive phytochemicals.


Fig. 1: Phyllanthus niruri L.
MATERIALS AND METHODS
Chemicals and reagents
Chemicals used were of analytical grade and included ethanol (PXpark Scientific,UK), methanol (Fisher Scientific,UK), chloroform (HPLC grade, Fisher Scientific,UK), hydrochloric acid (Berk Spencer, England), Mayer’s reagent, acetic anhydride (Sigma,USA), sulphuric acid (Fisher Scientific,UK), n- hexane (95% HPLC-PXpark Scientific, UK), acetone (PXpark Scientific,UK), petroleum ether (Fisher Scientific,UK), octanol and propanol (Sigma,USA), Ferric chloride (Berk Spencer, England), NH3 (Sigma,USA), pyridine, sodium nitroprusside, sodium hydroxide (Berk Spencer, England), Mueller Hinton agar, Mueller Hinton broth, peptone water, p-iodonitrotetrazolium chloride (INT)
Methods
Sample collection, identification and preparation
The whole plant of Phyllanthus niruri Lwas collected in November 2012 from farmlands in Tono near Navrongo in the Upper East Region of Ghana. Dr. Walter M. Kpikpi, a botanist in the Department of Applied Biology, University for Development Studies, Ghana, did the botanical identification.The plant samples were thoroughly washed with clean water to remove earthly materials and air-dried at room temperature for about three weeks. The various parts viz. the roots, the stems and the leaves were then separated. Dried samples were pulverized using pestle and mortar and a domestic electric grinder.
Extraction of plant material
Adequate quantity of each air-dried sample was mixed separately with 70% ethanol and 70% methanol for 3 days at room temperature with intermittent shaking. The suspensions were then filtered using 40 mesh screens and the filtrate concentrated using rotary evaporator. The concentrated crude extracts were freeze-dried and kept under refrigeration until further use.
Bacterial strain collection
Standard strains of six pathogenic microorganisms, Salmonella typhi, Staphylococcus aureus, Escherichia coli, Proteus mirabilis, Pseudomonas aeruginosa and Klebsiella pneumoniaewere collected from the Microbiology Laboratory of OkomfoAnokye Teaching Hospital, Kumasi-Ghana.
Qualitative phytochemical screening
Phytochemical screening was performed on the extracts using standard procedures as described by Trease and Evans [7-9].
Preparation of test organisms
Standard strains of S. typhi(ATCC19430), S. aureus(ATCC25923), P. mirabilis(ATCC49565), K. pneumoniae(ATCC33495), E. coli (ATCC25922), and P. aeruginosa (ATCC27853)were propagated on nutrient agar (Merck, 1.05450, Germany) plates and maintained on the plate at 2-4oC. Isolates were sub-cultured in Mueller-Hinton broth (Difco, 275730, France) at 37oC for 16 hours prior to antibacterial testing. 20 µL of these cultures were sub-cultured into 3 mL of sterile Mueller-Hinton broth and incubated at 37oC for another 2 hours. The turbidity of the actively growing broth cultures was adjusted with sterile Mueller-Hinton broth to obtain turbidity optically comparable to that of 0.5 McFarland Standard (approximately 1-2 x 108 CFU mL-1 for E. coli ATCC 25922).
Preparation of crude extracts and antibiotics
Exactly 400 mg of the plant extracts were dissolved in 1 mL 20% (v/v) sterile dimethylsulphoxide (DMSO) in order to obtain a stock concentration of 400 mg mL-1. The stock solution was further diluted using 20 % (v/v) DMSO in two-folds to obtain working concentrations of 200 mg mL-1 and 100 mg mL-1. DMSO was used as a negative control. Ciprofloxacin and chloramphenicol were prepared to final concentrations of 0.05 mg mL-1 and 0.30 mg mL-1 respectively and served as the positive drug controls against the bacteria.
Antimicrobial activity assay
The agar well diffusion method was used to investigate bacteria growth inhibition potentials of the crude extracts as described in the National Committee for Clinical Laboratory Standards (NCCLS) (2003). A sterilized cork borer of an internal diameter of about 6 mm was used to bore holes in the Mueller-Hinton agar (Oxoid, CM0337, Oxoid Ltd, England) plates. The extracts and control antibiotic, 0.05 mg mL-1 ciprofloxacin (Ernest Chemist, 101119-1, Tema, Ghana) and 0.30 mg mL-1 chloramphenicol powder (Fluka 23275, Sigma Aldrich, China) were dispensed into these holes. A triplicate of each plate was made. The plates were kept in a refrigerator for about 4 hours for complete diffusion of the extracts and the control antibiotics. The plates were then incubated at 37oC for 24 hours. After the incubation period, the diameter of each zone of inhibition was measured in millimeters (mm) with a sterilized ruler and the mean calculated.
Determination of Minimum Inhibitory Concentration (MIC)
The minimum inhibitory concentration of extracts and reference antibiotics were determined by using tetrazoliummicroplate assay with slight modification from serial broth microdilution method as previously described by Eloff[10]. This assay was performed using flat bottom 96-well clear microtitre plates. The wells in column 12 of each row were left blank and the remaining wells from column 1 to 11 were filled with 100 µL of sterile peptone water. 100 µL of 200 mg mL-1 solution of the extracts were added to the wells in column 1 of each row and identical two-fold serial dilutions were made from column 2 to column 11. The last wells in column 12 served as drug free controls. An appropriate solvent blanks (DMSO) were included as negative control. Lastly, 100 µL of bacterial inoculums were added in all the wells from column 1 to 12 and mixed thoroughly to give final concentrations ranging from 100 mg mL-1–0.0977 mg mL-1. Tests were done in duplicates. The cultured microplates were covered and incubated at 37oC for 24 hours. The MIC of samples were detected following the addition of 40 µL of 0.2 mg mL-1 p-iodonitrotetrazolium chloride (INT, Sigma-Aldrich, USA) and incubated at 37oC for 1 hour. Microbialgrowth was determined by observing the change of colour of p-iodonitrotetrazolium chloride (INT) in the microplate wells (pinkish-red forms when there is growth and clear solution when there is no growth). MIC was defined as the lowest sample concentration showing no colour change (clear) and exhibited complete inhibition of bacterial growth.
Statistical analysis
Data are expressed as mean ± SEM and were statistically analyzed using paired test. Statistical Analysis System (SAS) software was used to analyze the data from antimicrobial activities. P-values ≤ α (0.05) were considered significant.
RESULTS
The texture, colour and weight of the various methanolic and ethanol extracts of Phyllanthus niruri are presented in table 1. Table 2 presents the various secondary metabolites tested in preliminary phytochemical screening of the extracts of Phyllanthus niruri. All the extracts revealed the presence of phenols, saponins, flavonoids, terpenoids and triterpenoids. Cardiac glycosides, anthraquinones, phlobatannins, ketones and aldehydes were however absent in all the extracts.P. aeruginosa, E. coli, S. aureus, S. typhi, K. pneumoniae and P. mirabilis showed susceptibility to both ethanolic and methanolic extracts of P. niruri plant parts at 200 mg mL-1 Tables 3a and 3b. However at 200 mg mL-1, methanol root extract did not show activity against K. pneumoniae. Table 3c presents result for antimicrobial susceptibility test of the commercially available antibiotics, ciprofloxacin and chloramphenicol against the chosen microorganisms.
DISCUSSION
Classes of phytochemicals that have previously demonstrated potent bioactivities were present in the various extracts.Both methanol and ethanol extracts of whole plant and leaf showed the presence of alkaloids. Tannins and steroids were however present in the whole plant, the stem and the leaf except the root. The presence of alkaloids in the whole plant and the leaf ofP. nirurisuggest that the plant may show potent antibacterial and antifungal properties. The high amount of saponins in the plant may aid in reducing the burden of the liver with regards to cholesterol metabolism [11]. Flavonoids are reported to have antioxidant, anti-inflammatory and thrombocyte aggregation inhibitory effects [12]. The presence of terpenoids in the whole plant and the various parts make it potent against bacteria and fungi [12]. Plant extracts contain multitude of active compounds. Bacterial killing by these extracts may therefore be due to multiple mechanisms of inhibition.
Results of the present antimicrobial study suggests that both methanolic and ethanolic extracts of the whole plant are more effective against the test microorganisms than the various parts (stem, leaf and root), which show approximately the same inhibitory effect on the test pathogenic microorganisms. The results of the present study were in line with the scientific investigations byEkwenye and Njoku[13] that showed antibacterial effect of P.niruri againstE. coli, S. aureus and S. typhi.
Table 1: Texture, colour and weight of solvent soluble extracts obtained from Phyllanthus niruri
| Extracts | Texture | Colour | Weight (g) |
| Methanolic | |||
| Whole plant | Sticky | Dark brown | 2.50 |
| Root | Sticky | Dark brown | 2.00 |
| Stem | Sticky | Dark brown | 1.95 |
| Leaf | Sticky | Dark brown | 2.10 |
| Ethanolic | |||
| Whole plant | Sticky | Dark brown | 1.85 |
| Root | Sticky | Dark brown | 1.64 |
| Stem | Sticky | Dark brown | 2.40 |
| Leaf | Sticky | Dark brown | 1.90 |
Table 2: Preliminary phytochemical screening of parts of Phyllanthus niruri L
| Phytochemicals | Ethanol extracts | Methanol extracts | |||||
| W | R | S | L | W | R | S | |
| Alkaloids | ++ | - | - | + | ++ | - | - |
| Phenols | ++ | + | + | + | ++ | + | + |
| Saponins | ++ | + | + | + | ++ | + | + |
| Tannins | ++ | - | + | + | ++ | - | + |
| Steroids | ++ | - | + | + | ++ | - | + |
| Cardiac glycosides | - | - | - | - | - | - | - |
| Flavonoids | ++ | + | + | + | ++ | + | + |
| Terpenoids | ++ | + | + | + | ++ | + | + |
| Anthraquinones | - | - | - | - | - | - | - |
| Phlobatannins | - | - | - | - | - | - | - |
| Triterpenoids | ++ | + | + | + | ++ | + | + |
Legend: W=Whole plant; R=Root; S= Stem; L= Leaves, + = Slightly present; ++ = Moderately; present - = Absent
|
 |
|
|
|
|
|
|
|
Fig. 2: Zones of inhibition of Phyllanthus niruri L, extracts against the selected microorganisms.
 |
 |
 |
 |
 |
 |
Fig. 3: Microtitreplates showing how Minimum Inhibitory Concentrations (MICs) were determined.
Table 3a: Antimicrobial activity of ethanolicextracts on selected microorganisms
| Test organisms | Concentration (mg/mL) | Mean zones of inhibition | |||
| Ethanolic extracts | |||||
| Whole plant | Root | Stem | Leaf | ||
| S. typhi | 100200 | 26.4±0.429.4±0.4 | 12.5±0.525.0±0.0 | 13.5±0.524.3±0.3 | 19.5±0.523.5±0.5 |
| K. pneumoniae | 100200 | 16.3±0.322.7±0.0 | 0.010.5±0.5 | 0.010.3±0.3 | 0.011.0±0.0 |
| E. coli | 100200 | 20.0±0.029.0±1.0 | 14.6±0.626.0±0.0 | 13.9±0.023.5±0.5 | 17.7±0.025.0±0.0 |
| S. aureus | 100200 | 18.0±1.021.0±1.0 | 9.0±0.014.5±0.5 | 8.5±0.510.0±0.0 | 10.5±0.514.5±0.5 |
| P. mirabilis | 100200 | 17.0±1.021.2±0.2 | 8.5±0.512.0±0.0 | 9.0±0.014.0±1.0 | 9.9±0.913.5±0.5 |
| P. aeruginosa | 100200 | 17.5±0.523.6±0.6 | 12.0±0.020.0±0.0 | 13.3±0.320.0±1.0 | 14.0±1.020.0±0.0 |
Data expressed as mean ± SEM
The ethanolic and methanolic extracts of the whole plant of P. niruri, the stem, the root and the leaf showed zones of inhibition at 100 mg mL-1 and 200 mg/mL. On the basis of the MIC values, the whole plant extract was most effective against Staphylococcus aureus with MIC value of 1.56 mg mL-1 which makes S. aureus the most susceptible. The whole plant extracts were however less effective against the growth ofP. aeruginosa with MIC value of 50 mg/mL. Thus P. aeruginosa was the most resistant test organism. The variations in the activities (zones of inhibition) of the different extracts on the microorganisms could be due to the extent of distribution of the various phytochemicals present in the plant. Harisaranrajet al. [14] concluded that whole plant extract of P. niruri possessgood antimicrobial properties. Results from present investigation are in consonance with their findings. Phytochemical profile of P. niruri in the current research is also in agreement with the results of Sule and Agbabiaka [15]. The effect of Phyllanthus niruri extract corroborates the work of Contreras and Gamarra[16] on antibacterial effect of Phyllanthus niruri againstE. coli. A problem associated with many in vitro antibacterial studies of plant extracts is that, it is often difficult to elucidate the precise mechanism of action of inhibition because such extracts are complex mixtures of many secondary plant products. However, several studies have shown that the most common mechanisms of inhibition includeinhibition of cell wall synthesis, inhibition of protein synthesis, alteration of cell membranes,inhibition of nucleic acid synthesis and antimetabolite activity. Therefore, P. niruri extracts might be acting through one or more of these mechanisms in inhibiting the growth of the susceptible bacteria.
Table 3b: Antimicrobial activity of methanolic extracts on selected microorganisms.
| Test organisms | Concentration(mg/mL) | Mean zones of inhibition (mm) | |||
| Methanolic extracts | |||||
| Whole plant | Root | Stem | Leaf | ||
| S.typhi | 100200 | 22.5±0.528.8±0.0 | 10.0±0.015.0±0.0 | 15.0±0.025.0±0.0 | 15.5±0.524.5±0.5 |
| K. pneumoniae | 100200 | 14.6±0.021.0±1.0 | 0.00.0 | 9.0±1.019.0±1.0 | 0.08.0±1.0 |
| E. coli | 100200 | 19.7±0.027.9±0.0 | 15.8±0.025.5±0.5 | 16.0±1.026.0±1.0 | 14.5±0.524.0±0.0 |
| S.aureus | 100200 | 15.6±0.018.9±0.0 | 8.0±1.014.5±0.5 | 7.5±0.514.0±0.0 | 0.09.5±0.5 |
| P. mirabilis | 100200 | 14.4±0.019.0±1.0 | 8.0±1.012.5±0.5 | 9.0±1.014.0±0.0 | 8.0±0.010.5±0.5 |
| P.aeruginosa | 100200 | 19.0±1.029.0±1.0 | 12.5±0.520.0±0.0 | 19.0±1.027.0±0.0 | 17.5±0.524.0±0.0 |
Data expressed as mean ± SEM
Table 3c: Zones of inhibition of commercially available antibiotics on selected microorganisms
| Test organisms | Mean zones of inhibition (mm) | ||
| DMSO20 % V/V | Ciprofloxacin 0.05 mg/ mL | Chloramphenicol0.30 mg/mL | |
| S.typhi | 0.0 | 44.3±0.30 | 0.0 |
| K. pneumoniae | 0.0 | 30.0±0.00 | 21.0±0.00 |
| E. coli | 0.0 | 34.5±0.50 | 15.3±0.30 |
| S. aureus | 0.0 | 40.0±0.00 | 0.0 |
| P.mirabilis | 0.0 | 35.3±0.30 | 11.0±0.00 |
| P.aeruginosa | 0.0 | 33.5±0.50 | 19.0±0.00 |
Data expressed as mean ± SEM
Table 4: Minimum Inhibitory Concentrations (MICs) of the ethanol extract of Phyllanthus niruri
| Test organisms | MIC (mg mL-1) | |||
| Whole plant | Leaf | Stem | Root | |
| K.pneumonia | 12.5 | 25.0 | 50.0 | 25.0 |
| E.coli | 6.25 | 12.5 | 12.5 | 12.5 |
| S.aureus | 1.56 | 3.125 | 6.25 | 6.25 |
| P. mirabilis | 6.25 | 12.5 | 12.5 | 25.0 |
| P.aeruginosa | 25.0 | 50.0 | 50.0 | 50.0 |
| S. typhi | 6.25 | 12.5 | 25.0 | 25.0 |
CONCLUSION
Extracts of various parts of Phyllanthus niruri have shown significant broad-spectrum antimicrobial properties against some selected bacteria. Whole plant extract of P. niruri demonstrated the greatest antibacterial activity with the root extract being the least active. The antibacterial activities shown by the various extracts may be attributed to the some ofthe phytochemicals present. In conclusion, results from the present study supports folkloric use of P. niruri in the treatment of bacterial related infections and also presents the plant as a credible candidate for subsequent isolation of novel antibacterial compounds. We intend to further evaluate the antibacterial activity of the plant against a wider range of microbes. Investigation leading to subsequent isolation and characterization of the bioactive compounds in the plant is desired.
CONFLICT OF INTERESTS
Declared None
ACKNOWLEDGEMENT
Our profound gratitude goes to the Centre for Scientific Research into Plant Medicine, AkuapemMampong, Ghana, particularly to the workers in the Departments of Microbiology and Phytochemistry. Special thanks goes to Dr. Boamah Daniel, Mr. Kaminta Sylvester, Mr. Somuah Samuel, Mrs. AchaempongSalomey and Mr. Richard Adeglefor the support they provided in diverse ways in the course of our research. We are also grateful to authors of articles we have cited in this manuscript for the valuable literature.
REFERENCES
- Prusti A, Mishra SR, Sahoo S, Mishra SK. Antibacterial activity of some indian medicinal plants. J Ethnobotanical Leaflets 2008;12:227-30.
- Ebi GC, Ofoefule SI. Antimicrobial activity of Pterocarpusosun stems. J Fitoterapia 2002;71:433-35.
- Hostettmann K, Humburger M. Antimicrobial effects of some native plants. J Phytochemistry 1991;30:3864-74.
- Freitas AM, Schor N, Boim MA. The effect of Phyllanthus niruri on unirary inhibitors of calcium oxalate crystallization and other factors associated with renal stone formation. British J of Urology Int 2002;89 (9):829-34.
- Oliver-Beaver B. Medicinal plants in tropical West Africa1986.
- Paranjape P. Indian medicinal plants:Forgotten Healers. Delhi Chaukhamba Sanskrit Pratisthan. 2001.
- Trease GE, Evans WC, B. W. Introduction and general methods in Pharmacognosy1996.
- Harborne JB. Phytochemical methods:A guide to modern techniques1973.
- Sofowora A. Medicinal plants and Traditional medicine in Africa1993.
- Ellof JN. A sensitive and quick microplate method to determine minimum inhibitory concentration of plant extracts for bacteria. J Planta Med 1998;64:711-13.
- Prince KR and Johnson L. Phytochemical Methods. J Science and Nutrition 1987;26:127-35.
- Wagner H, Elbl G, lotter H and Guinea M. Phytochemicals, mineral content and antimicrobial screening of Phyllanthus amarus Schum and Thonn in Abuja, Nigeria. J Pharmacy and Pharmacological Letters 1991;1:15.
- Ekwenye UN, Njoku NU. Antimicrobial effect of Phyllanthus niruri (Chancapiedra) on three enteropathogens in man. Int J of Molecular Medicine Adv in Sci 2006;2 (2):184-9.
- Harisaranraj R, Babu SS, Suresh K. Antimicrobial properties of selected Indian medicinal plants against acne-inducing bacteria. J Ethnobotanical Leaflets 2010;14:84-94.
- Sule IO and Agbabiaka TO. Antibacterial effect of some plant extracts on selected enterobacteriaceae. J Ethnobotanical Leaflets 2008;12:1035-42.
- Contreras J, Gamarra S, M. J. Determination of microbial limits and of the antimicrobial activity of species:Phyllanthus niruri UN. MPeru.